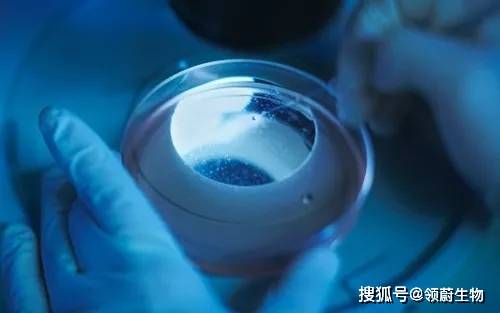
功能|干细胞是肺纤维化的“清道夫”，是肺损伤患者的福音

功能|干细胞是肺纤维化的“清道夫”,是肺损伤患者的福音
肺纤维化是以成纤维细胞增殖及大量细胞外基质聚集并伴炎症损伤、组织结构破坏为特征的一大类肺疾病的终末期改变 , 也就是正常的肺泡组织被损坏后经过异常修复导致结构异常(疤痕形成) 。
文章图片
绝大部分肺纤维化病人病因不明(特发性) , 这组疾病称为特发性间质性肺炎 , 是间质性肺病中一大类 。
而特发性间质性肺炎中最常见的以肺纤维化病变为主要表现形式的疾病类型为特发性肺纤维化 , 是一种能导致肺功能进行性丧失的严重的间质性肺疾病 。
肺纤维化严重影响人体呼吸功能 , 表现为干咳、进行性呼吸困难(自觉气不够用) , 且随着病情和肺部损伤的加重 , 患者呼吸功能不断恶化 。

文章图片
特发性肺纤维化发病率和死亡率逐年增加 , 诊断后的平均生存期仅2.8年 , 死亡率高于大多数肿瘤 , 被称为一种“类肿瘤疾病” 。
多种原因引起肺脏损伤时 , 间质会分泌胶原蛋白进行修补 , 如果过度修复 , 即成纤维细胞过度增殖和细胞外基质大量聚集 , 就会形成肺纤维化 。
1、过敏性肺炎、尘肺病;
2、胺碘酮、博来霉素、甲氨蝶呤等药物;
3、结缔组织基本、血管炎、特发性非特异性间质性肺炎等;
4、吸烟、病毒感染、胃食管反流、衰老等都与肺纤维化有关 。

文章图片
01
临床表现
肺纤维化多在40~50岁发病 , 男性多发于女性 。 呼吸困难是肺纤维化最常见症状 。 轻度肺纤维化时 , 呼吸困难常在剧烈活动时出现 , 因此常常被忽视或误诊为其他疾病 。
当肺纤维化进展时 , 在静息时也发生呼吸困难 , 严重的肺纤维化患者可出现进行性呼吸困难 。 其他症状有干咳、乏力 。
部分患者有杵状指和发绀 。 肺组织纤维化的严重后果 , 导致正常肺组织结构改变 , 功能丧失 。
当大量没有气体交换功能的纤维化组织代替肺泡 , 导致氧不能进入血液 。 患者呼吸不畅 , 缺氧、酸中毒、丧失劳动力 , 严重者最后可致死亡 。

文章图片
02
干细胞技术如何治疗肺纤维化?
来自北卡罗莱纳州立大学的一项最新研究表明 , 通过雾化吸入的方式输送肺干细胞分泌物(包括外泌体和和其他细胞分泌因子)可修复小鼠和大鼠因肺纤维化所致的肺损伤 , 这项工作为肺纤维化患者提供了一种潜在的无创治疗手段 。
研究人员发现 , 与生理盐水对照组相比 , 治疗后的肺纤维化减少了近50% , 达到了完全缓解(与健康组无统计学差异) 。
间充质干细胞是干细胞家族的重要成员 , 来源于早期的中胚层和外胚层 , 最初在骨髓中发现 , 具有多向分化潜能、造血支持和促进干细胞植入、免疫调控和自我复制等特点 。

文章图片
【功能|干细胞是肺纤维化的“清道夫”,是肺损伤患者的福音】 间充质干细胞具有强大的抗炎和免疫调节功能 , 通过抑制肺部浸润的免疫细胞减轻
慢性肺损伤 , 并降低炎性因子分泌水平 。
同时通过分泌干细胞生长因子等因子 , 促进肺损伤中的肺泡上皮屏障的修复 , 增强肺组织损伤修复能力 , 进一步降低肺部纤维化水平 。
- 血压|主动脉夹层可夺命?这五类人是高危人群,需高度重视
- 进行|尿毒症多半是“吃”出来的?3种食物尽量少碰,肾或许“感谢”你
- 按摩|你知道吗?间充质干细胞可以改善失眠症状
- 苹果是天然润唇膏 你知道吗?
- 生活|提醒:肝病多数是“拖”出来的,出现6种表现,最好查一下肝功
- 羊肉|羊肉到底是“致癌杀手”还是“营养佳品”呢?世卫组织揭晓答案
- 肠镜|肠镜选无痛好还是普通好?二者有何区别?不妨听听医生的分析!
- 疫情|切莫上当!这些都是流调员绝不会问的问题
- 心血管疾病|这个病还是“夫妻病”,你知道吗?
- 跑步有效延长寿命,但是晨跑和夜跑哪一个好?这才是最佳时间
